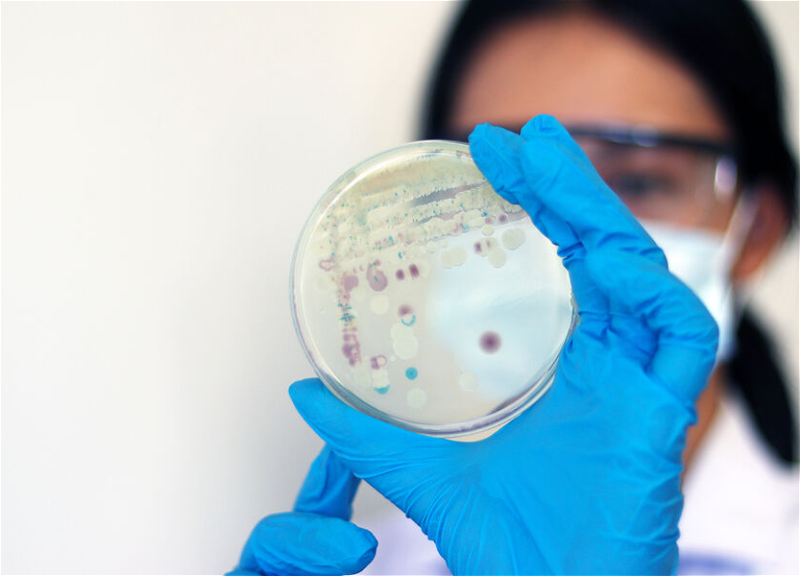

МВД РФ объявило в розыск Евгения Киселева
Журналист и медиаменеджер Евгений Киселев, признанный в России иноагентом, объявлен в розыск.
Это следует из базы розыска МВД России.
«Киселев Евгений Алексеевич, 15 июня 1956 года рождения, разыскивается по статье УК», - говорится в базе розыска МВД без уточнения конкретной статьи.
Минюст России включил Киселева в список лиц, выполняющих функцию иностранного агента, в начале апреля. В обосновании включения в список Киселева было указано «осуществление политической деятельности», а иностранным источником указана Украина.
Киселев - журналист, медиаменеджер и политический обозреватель. Работать на телевидении начал с 1984 года. С 1993-го по 2001 год являлся сотрудником телеканала НТВ. В настоящее время Киселев работает на телеканале «Украина-24».
Источник: ТАСС